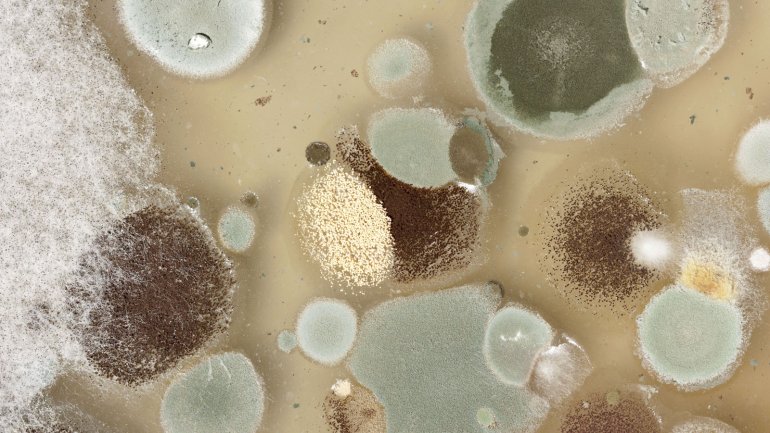

Aspergillus
Der Schimmelpilz Aspergillus ist weltweit verbreitet und kommt überall im Boden, auf faulenden Pflanzen, in der Erde von Topfpflanzen sowie auf Getreide und Nüssen vor.
Dieser Text entspricht den Vorgaben der ärztlichen Fachliteratur, medizinischen Leitlinien sowie aktuellen Studien und wurde von Mediziner*innen geprüft.
Überblick
Aspergillen findet man außerdem in großen Mengen in Komposthaufen und Kompostieranlagen und in verschimmelten Lebensmitteln. Häufig werden die Sporen auch über schlecht gewartete Klimaanlagen verbreitet. Baustaub enthält große Mengen an Aspergillus-Sporen (Konidien), daher stellen Baustellen eine mögliche Schimmelpilz-Infektionsquelle für den Menschen dar.
Die Sporen von Aspergillus gelangen über die Atemluft in den Körper des Menschen. Da sie sehr klein sind, können sie bis zu den Lungenbläschen (Alveolen) gelangen. Aber auch über Verletzungen der Haut und Schleimhäute können die Aspergillus-Sporen Zugang zum Körper bekommen. Solange das Immunsystem intakt ist, machen Schimmelpilze den Menschen nicht krank. Die Sporen werden ohne Probleme vom Körper bekämpft. Eine sehr starke Schimmelbelastung wie zum Beispiel in der Biotonne oder bei Feuchtigkeitsansammlung in Wohn- und Kellerräumen kann allerdings Atemwegprobleme wie Asthma hervorrufen. Bei immungeschwächten Menschen kann der Schimmelpilz Aspergillus überleben und sich in der Lunge, im Gehörgang oder in der Schleimhaut der Nasennebenhöhlen festsetzen und je nach Lokalisation ein Lungen-Aspergillom, eine Mykose des äußeren Gehörgangs oder der Nasennebenhöhlen auslösen. Der Pilz kann sich außerdem auf das zentrale Nervensystem ausweiten. Eine Infektion mit Aspergillus-Arten nennt sich Aspergillose.
Für den Menschen sind vor allem die Arten Aspergillus fumigatus, Aspergillus niger, Aspergillus flavus und Aspergillus nidulans von medizinischer Bedeutung. Darüber hinaus gibt es noch etwa 200 weitere Aspergillus-Arten.
Aspergillus bildet ein Geflecht (Myzel) aus gabelig verzweigten Pilzzellen (Hyphen). Auf einfachen Nährböden wachsen nach zwei bis sieben Tagen Kulturen der Aspergillen. Aspergillus fumigatus bildet dabei wattig-pudrige Kolonien, deren Farbe je nach Alter zwischen rauchgrau und braun liegt.
Krankheiten
Aspergillus-Sporen gelangen vor allem mit der Atemluft in die Lunge. Sie können aber auch über Verletzungen der Haut oder Schleimhäute in den Körper gelangen. Die Sporen können vor allem bei bereits geschwächtem Immunsystem zur sogenannten Aspergillose führen, die sich in unterschiedlichen Körperbereichen zeigen kann. Unter Umständen bildet sich in Körperhohlräumen ein Knoten aus Pilzhyphen, ein sogenanntes Aspergillom.
Aspergillom in den Nasennebenhöhlen
Ein Aspergillom in den Nasennebenhöhlen tritt häufig bei bereits bestehender chronischer Nasennebenhöhlenentzündung (Sinusitis) auf. Durch die schon vorhandenen Krankheitserscheinungen merken Betroffene oft nichts von dem Befall. Unter Umständen können durch das Aspergillom neben der bestehenden Infektion weitere Infektionen auftreten und es kann zu einer sogenannten Superinfektion kommen. Bei eingeschränkter Immunabwehr können die Aspergillen in die Knochen eindringen und sich bis ins Gehirn ausbreiten.
Aspergillom in der Lunge
Ein Aspergillom in der Lunge tritt meist bei schon bestehenden Lungenerkrankungen auf, wie zum Beispiel bei Bronchialkarzinom, Tuberkulose oder wiederkehrenden bakteriellen Lungenentzündungen (Pneumonie). Durch solche Erkrankungen haben sich meist Hohlräume in der Lunge gebildet, die nicht mit Bronchialschleimhaut bedeckt sind und in denen sich die Aspergillen gut ansiedeln können. Die Symptome hängen dabei von der jeweiligen Grunderkrankung ab.
Allergische bronchopulmonale Aspergillose
Durch den Befall der Lunge mit Aspergillus-Sporen kann bei Grunderkrankungen wie akutem Asthma bronchiale und Mukoviszidose eine allergische bronchopulmonale Aspergillose entstehen. Allergische bronchopulmonale Aspergillosen äußern durch Symptome wie Husten und Auswurf. Im Röntgenbild zeigen sich netzartige, streifenförmige Schatten. Betroffene reagieren bei Hautkontakt mit Aspergillus allergisch.
Vorbeugen
Aspergillus im Haushalt oder in der Umwelt kann man praktisch kaum vorbeugen. Um eine Besiedelung durch den Schimmelpilz Aspergillus zu vermeiden, sollten der Kontakt zu Infektionsquellen eingeschränkt und zum Beispiel Filter von Klimaanlagen regelmäßig gewechselt werden.
Anfällige Personen sollten auf Zimmerpflanzen verzichten. Auch in Krankenhauszimmern sollten keine Topfpflanzen stehen.